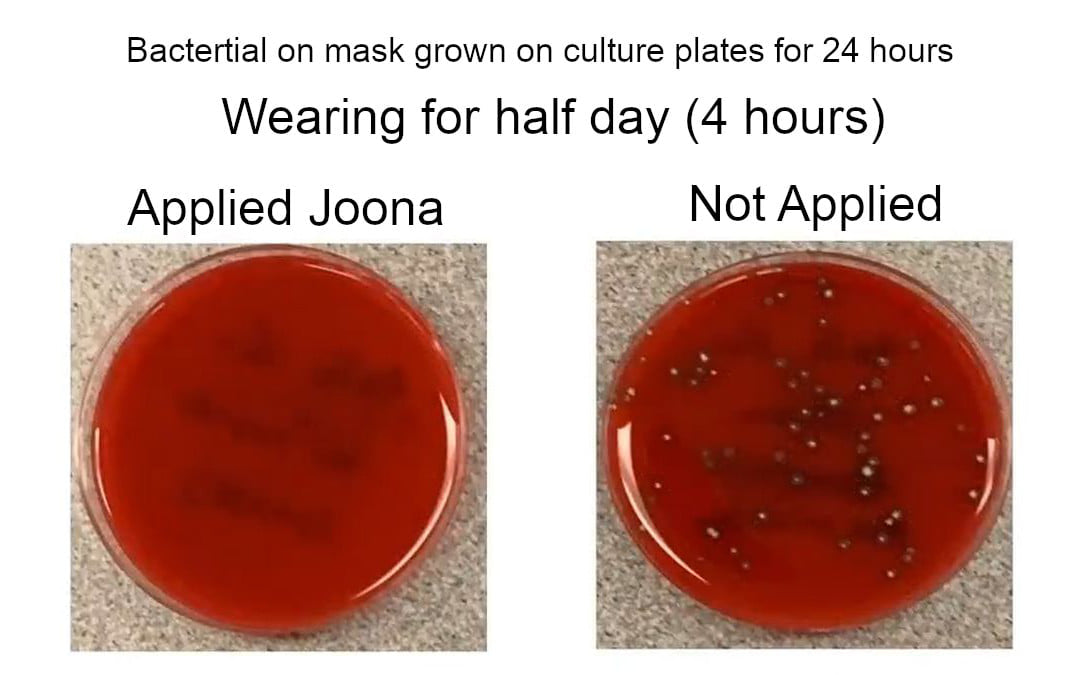

Coronavirus: Tips to Avoid "Maskne" Skin Irritation - Joona Spray will keep your mask clean. It kills 99.999% germs with food grade ingredient to ensure health & safety.
Wearing a face mask is an important way to lessen the spread of the coronavirus that causes COVID-19. As the pandemic continues, more evidence shows the effectiveness of masks, and more places require people to wear them. Since masks are essential, it’s important to do whatever we can to overcome concerns about wearing them. Sometimes, for some people, wearing a mask can cause — or worsen — breakouts, rashes and other skin problems on the face.
Though so-called “maskne” (mask + acne) isn’t always related to acne, you might notice some facial breakouts as a possible side effect of mask use. Anna Chien, M.D., dermatologist in the Johns Hopkins Department of Dermatology, explains how you can care for facial skin problems while protecting yourself and others by wearing a mask.
Who is more likely to get skin problems from wearing a face mask?Chien points out that people might be more likely to experience face-mask-related bumps and rashes if they’re already living with skin issues, such as:
RosaceaAcneAtopic dermatitis, also known as eczemaSensitivity to humid or dry airAllergiesThe skin around the nose, mouth and chin — the places covered by a face mask — is very delicate, Chien explains. “One thing we’re seeing more often these days is perioral dermatitis, a condition similar to rosacea,” Chien says.
People with perioral dermatitis have recurring bouts of a red, bumpy rash around their mouth and chin. The area around the eyes can be affected, too. Women between ages 20 and 60 are most likely to have the condition, and the cause is unknown. Steroid medicine may be the culprit in some cases.
Make sure your mask fits properlyAn important part of wearing your mask properly is ensuring that it fits your face and covers both your nose and your mouth. To help avoid chafing, your face mask shouldn’t gap excessively. But it shouldn’t be too tight either.
Masks with ties can be easier to adjust to the size and shape of your face. A bendable piece across the bridge of the nose can help ensure a good fit and keep the mask from fogging up your glasses, but it can also chafe the nose if it is not cushioned by fabric.
Keep your mask(s) cleanOil, nasal mucus, saliva and sweat can get on your face mask wherever it touches your face. Wash your mask with gentle, nonirritating soap after each use and dry it in the dryer. Store your fresh masks in a bag to keep them clean.
“Maskne” Skin Care Routine“If you’re concerned about breakouts, I recommend gentle, mild soaps and water for your face, nothing scented or antibacterial,” Chien says. “Try a good, bland moisturizer at night.“
“For anyone who starts to get irritation on their facial skin, use a barrier cream or spray, such as petroleum jelly or zinc oxide,” Chien says. “I like diaper cream, because you’re pretty much addressing the same issue as diaper irritation: irritated, raw, sore skin due to a warm, wet environment.”
If you know you’ll be spending time with a mask on, consider taking a break from unnecessary cosmetics. Since no one will see the lower half of your face, it’s a perfect time to skip makeup or anything that could clog your pores or aggravate acne or other skin lesions.

